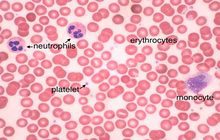

Histological services, tissue engineering and pathology staining
- Preparation of paraffin and frozen tissue sections in different sizes
- General and specialized tissue and cell staining
- Immunocytochemistry (ICC) technique
- Immunohistochemistry (IHC) technique
- Perform tunnel technique to evaluate apoptosis
- Preparation of sections from chemical and natural tissue scaffolds
- Prepare educational slides for students from all available tissues
- Examination of cell placement on tissue scaffolds with SEM microscopy
- Preparation of tissue sections for examination with a TEM microscope

Histological methods includes sample processing in the pathology laboratory, preparation of the slide and its examination under a microscope, sample fixation, molding, microtome cutting, staining and assembly of the slides.
On the other hand, in cutting-edge sciences such as tissue engineering, the use of up-to-date techniques for section preparation and cell tracking and engineered tissue structure has contributed significantly to the development of new studies.